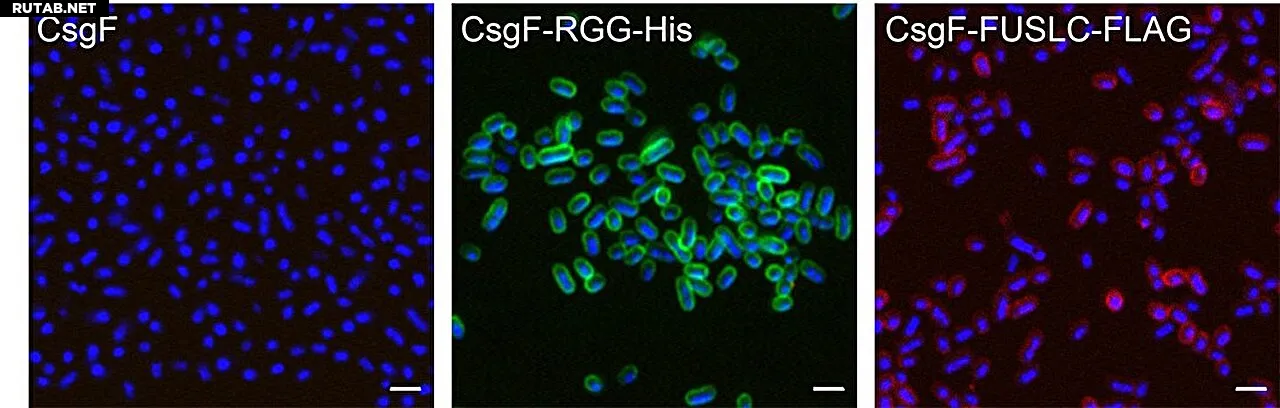

Ученые научили бактерии E. coli формировать структуры по команде
Микрофотографии «вспомогательного белка» CsgF, связывающего неупорядоченные белки RGG (зеленый) и FUSLC (красный) с поверхностью E. coli. «His» и «FLAG» указывают на окраску клеток для визуализации. Автор: Proceedings of the National Academy of Sciences (2025). DOI: 10.1073/pnas.2510167122
Исследователи из Северо-Восточного университета модифицировали бактерии кишечной палочки (E. coli), чтобы те могли формировать структуры под внешним контролем. Ученые использовали так называемые неупорядоченные белки, которые действуют как тонкие волоски, связывая клетки друг с другом.
Аспирант Ронг Чанг объясняет, что изменяя условия окружающей среды, экспериментаторы могли «достичь обратимой клеточной организации». Это означает, что клетки можно было заставить принять определенную форму, затем изменить ее на вторую, а после — вернуть к исходной конфигурации. По словам Чанга, такие результаты «ранее никогда не сообщались».
От каркасов к прямому контакту
Доцент Ниил Джоши отмечает, что одна из главных целей в инженерии живых материалов — «строить структуры, как это делает биология». В отличие от растительных клеток, которые используют полимеры вроде целлюлозы для жесткости, его команда сосредоточилась на более сложной задаче — манипулировании прямыми контактами между клетками.
Ключевой белок-якорь
Чанг нашел способ использовать «вспомогательный белок» CsgF в качестве якоря на внешней поверхности клетки E. coli. Неупорядоченные белки, не имеющие определенной трехмерной формы, прикрепляются к поверхности клетки и, словно водоросли, колеблются вокруг нее. Когда две клетки сближаются, эти «волоски» сцепляются, «как липучка», объясняет Джоши.
Платформа для будущих открытий
Чанг называет их открытие платформой для создания других полезных материалов. «Неупорядоченные белки можно применять для различных функций», — говорит он. Например, многие антифризные белки являются неупорядоченными. Включение их в искусственную клеточную структуру может позволить создавать материалы, способные выдерживать экстремально низкие или высокие температуры.
«Если мы сможем применить эти белки в нашей системе, мы поможем клеткам расти в очень суровых условиях», — заключает Чанг.
Больше информации: Rong Chang et al, Programming cellular condensates for living materials using an intrinsically disordered protein display platform, Proceedings of the National Academy of Sciences (2025). DOI: 10.1073/pnas.2510167122

0 комментариев